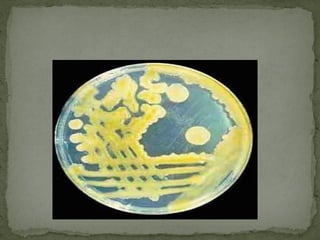

El documento describe los conceptos básicos de la agroecología, incluyendo factores bióticos como el clima, la luz y la temperatura que son condiciones para la vida. También cubre la ecología de poblaciones, comunidades y el funcionamiento de los ecosistemas, con énfasis en el flujo de energía y los ciclos biogeoquímicos.